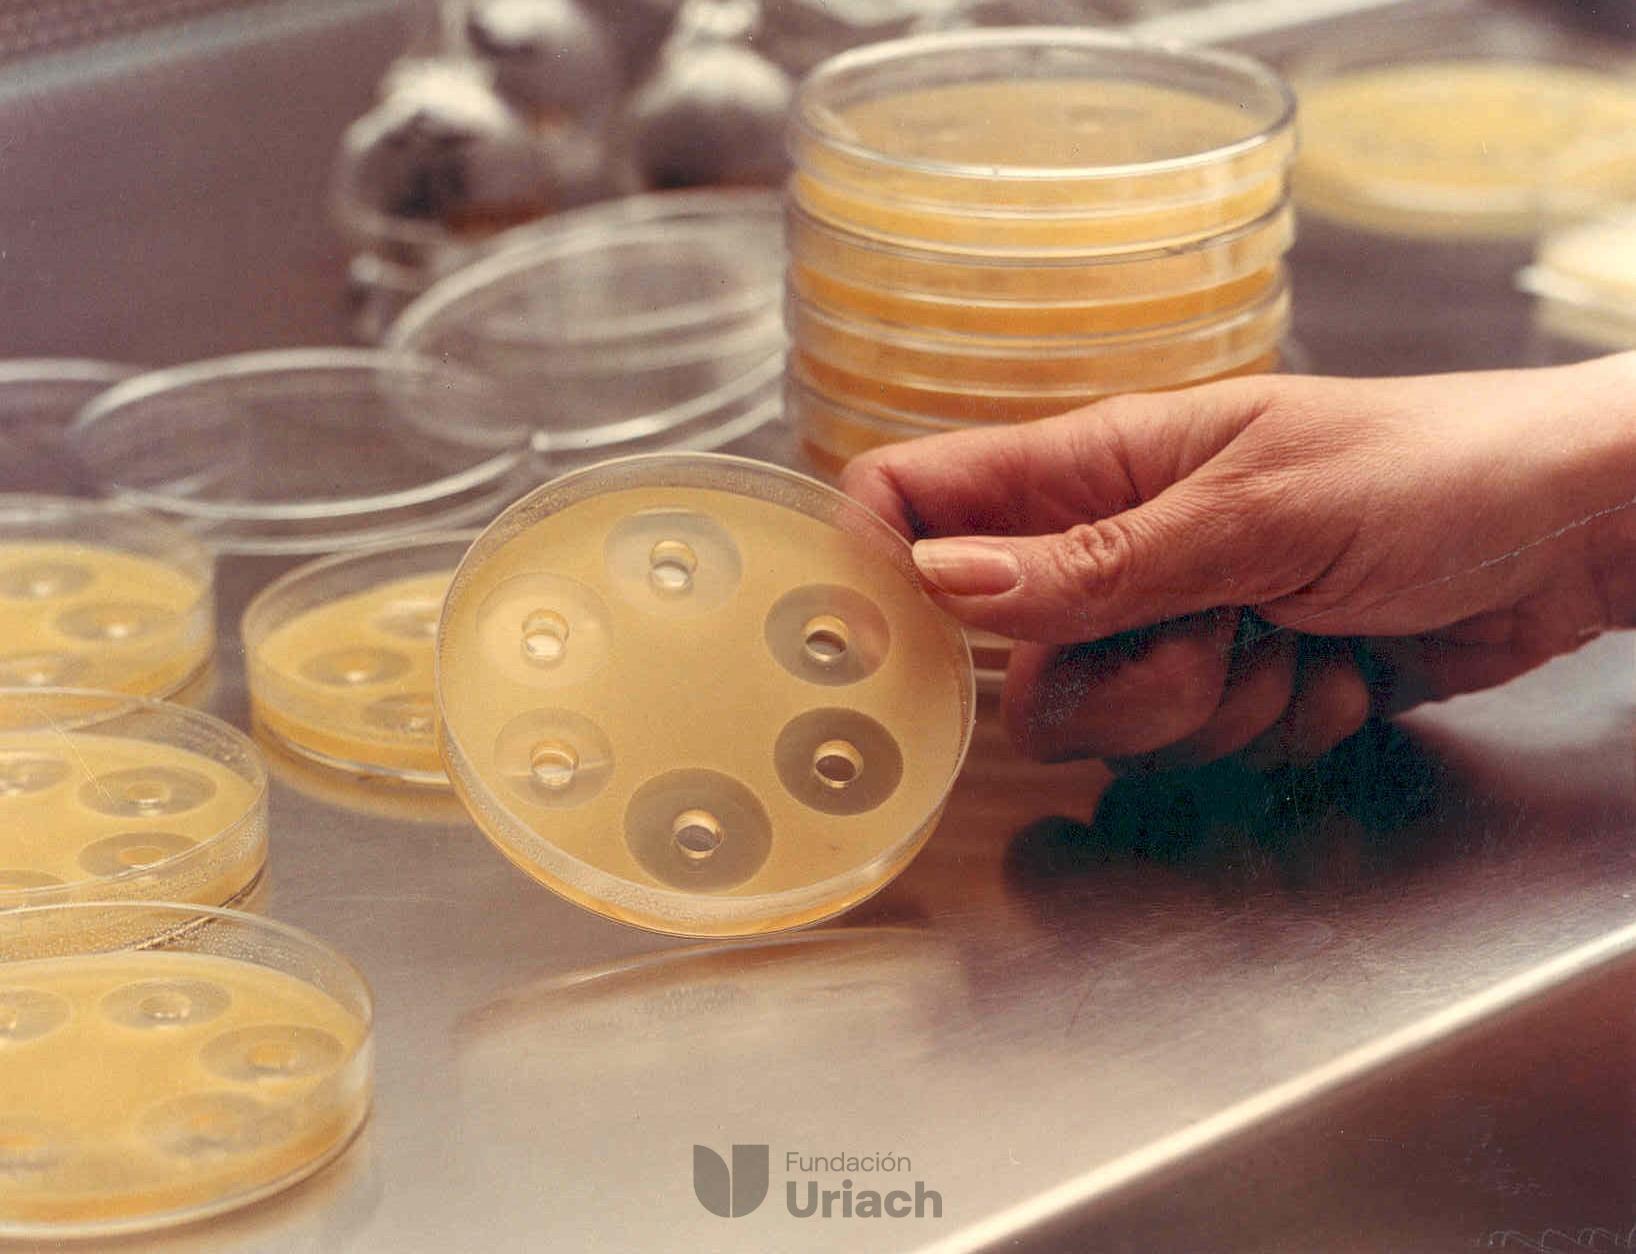

Neix a Valls, però aviat es trasllada a Barcelona, on treballa per a diverses revistes i publicacions com Destino, Gaceta Ilustrada o La Vanguardia. El 1953 realitza la seva primera exposició individual i, des d’aleshores, il·lustra un gran nombre de llibres, especialment d’art.
La seva obra ha estat reconeguda amb nombrosos premis, com el Premi Ciutat de Barcelona (1951 i 1952), els Premis Nacionals de les Arts Plàstiques del Ministeri de Cultura (1983) i de la Generalitat de Catalunya (1991), la Creu de Sant Jordi (1992) i la Medalla d’Or al Mèrit Artístic (1993).